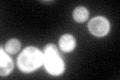
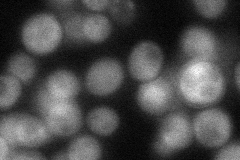
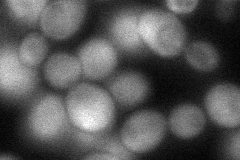
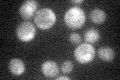

View description
Gamma-glutamyl kinase, catalyzes the first step in proline biosynthesis
Localization:
Intensity:
Fold change:
Significance:
-
C’ GFP library in SD
cytosol95.19 -
N' NOP1pr-GFP in SD

cytosol103.767 -
N' TEF2pr-mCherry in SD

cytosol163.65 -
N' NATIVEpr-GFP in SD
cytosol55.6323 -
N' TEF2pr-VC and Cyto-VN in SD
cytosol65.4894 -
C’ GFP library in SD+DTT

cytosol69.970.73No -
C’ GFP library in SD+H2O2

cytosol94.010.98No -
C’ GFP library in Starvation Media
cytosol34.860.36No -
C’ GFP library on the background of Pup2-DaMP

cytosol -
C’ GFP library on the background of CCT mutant

cytosol112.7661.18449No
